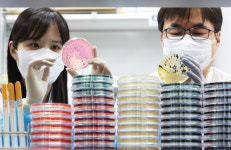
‘뭘 먹었길래?’···건국대 학생식당 밥 먹고 10여명 식중독 증상

먹고식당 총140명이 열람하였으며, 0개의 리뷰가 있습니다.
- 가맹점명
- 먹고식당
- 가맹점유형코드
- 1
- 시도명
- 부산광역시
- 시군구명
- 부산진구
- 시군구코드
- 26,230
- 소재지도로명주소
- 부산광역시 부산진구 중앙대로621번길 25
- 소재지지번주소
- 부산광역시 부산진구 범천동 871-1
- 전화번호
- 000-0000-0000
- 평일운영시작시각
- 09:00
- 평일운영종료시각
- 23:59
- 토요일운영시작시각
- 09:00
- 토요일운영종료시각
- 23:59
- 공휴일운영시작시각
- 09:00
- 공휴일운영종료시각
- 23:59
- 배달시작시각
- 09:00
- 배달종료시각
- 23:59
- 관리기관명
- 부산광역시 부산진구청
- 관리기관전화번호
- 051-605-4862
- 데이터기준일자
- 2024-05-17
- 제공기관코드
- 3,290,000
- 제공기관명
- 부산광역시 부산진구
주변 목록 (8)
메밀꽃 일다
부산광역시 부산진구 중앙대로621번길 17
'먹고식당'에서 0km
부산광역시 부산진구 중앙대로621번길 17
바로가기
해동식당
부산광역시 부산진구 신천대로71번길 39
'먹고식당'에서 0km
부산광역시 부산진구 신천대로71번길 39
바로가기
행운식당
부산광역시 부산진구 신천대로71번길 39-1
'먹고식당'에서 0km
부산광역시 부산진구 신천대로71번길 39-1
바로가기
메추삼계탕
부산광역시 부산진구 신천대로65번길 43
'먹고식당'에서 0km
부산광역시 부산진구 신천대로65번길 43
바로가기
마당쇠돼지꼬리
부산광역시 부산진구 신천대로65번길 64
'먹고식당'에서 0.1km
부산광역시 부산진구 신천대로65번길 64
바로가기
남원추어탕
부산광역시 부산진구 신천대로65번길 63
'먹고식당'에서 0.1km
부산광역시 부산진구 신천대로65번길 63
바로가기
에이미트부산지사
부산광역시 부산진구 중앙대로621번길 7-5
'먹고식당'에서 0.1km
부산광역시 부산진구 중앙대로621번길 7-5
바로가기
연선생
부산광역시 부산진구 중앙대로621번길 7
'먹고식당'에서 0.1km
부산광역시 부산진구 중앙대로621번길 7
바로가기
주변 관광 음식점 (7)
슈퍼스타마마
울산광역시 남구 삼산동 1564-11번지 2층
'먹고식당'에서 50.66km
바로가기
레드카
대구광역시 동구 신천동 314-3
'먹고식당'에서 89.1km
바로가기
클럽볼륨
전북특별자치도 무주군 설천면 심곡리 1209-22 중앙상가 A-5동 2-26
'먹고식당'에서 145.28km
바로가기
스카이슈퍼돔관광나이트클럽
충청남도 천안시 서북구 불당동 684-1번지
'먹고식당'에서 254.81km
바로가기
자유의 여신
경기도 수원시 팔달구 인계동 1133-8
'먹고식당'에서 296.73km
바로가기
라운딩
제주특별자치도 제주시 연동 262-14
'먹고식당'에서 299.61km
바로가기
뮤직&바
강원특별자치도 고성군 토성면 신평리 202-15
'먹고식당'에서 347.29km
바로가기
주변 외국인 전용 음식점 (12)
말리부
부산광역시 동구 초량동 483
'먹고식당'에서 3.86km
바로가기
보라카이
부산광역시 동구 초량동 486-2
'먹고식당'에서 3.88km
바로가기
엔젤레스
부산광역시 동구 초량동 486-2 1층
'먹고식당'에서 3.88km
바로가기
바이칼
부산광역시 동구 초량동 488-1
'먹고식당'에서 3.89km
바로가기
라스베가스
부산광역시 동구 초량동 489-1
'먹고식당'에서 3.91km
바로가기
파라다이스
부산광역시 동구 초량동 465-20
'먹고식당'에서 3.92km
바로가기
런던
부산광역시 동구 초량동 1207-16
'먹고식당'에서 3.94km
바로가기
킹스
부산광역시 동구 초량동 493
'먹고식당'에서 3.95km
바로가기
허리웃
부산광역시 동구 초량동 493
'먹고식당'에서 3.95km
바로가기
모니카
부산광역시 동구 초량동 500-1
'먹고식당'에서 4.02km
바로가기
하바나
부산광역시 동구 초량동 1208-14
'먹고식당'에서 4.02km
바로가기
발리
부산광역시 동구 초량동 500-1
'먹고식당'에서 4.02km
바로가기
주변 관광 식당 (12)
(주)해운대 암소갈비집
부산광역시 해운대구 중동 1225-1
'먹고식당'에서 10.02km
바로가기
대동할매국수
경상남도 김해시 대동면 초정리 952-25
'먹고식당'에서 11.46km
바로가기
향옥정
경상남도 김해시 불암동 192-1
'먹고식당'에서 14.39km
바로가기
경포장장어구이
경상남도 김해시 불암동 229-34
'먹고식당'에서 14.59km
바로가기
제이더블유웨딩컨벤션(주)
경상남도 김해시 삼정동 315
'먹고식당'에서 16.65km
바로가기
가야마루
경상남도 김해시 어방동 1104-9
'먹고식당'에서 16.87km
바로가기
수손짜장
경상남도 김해시 어방동 1062-10
'먹고식당'에서 16.94km
바로가기
(주)초마김해점
경상남도 김해시 외동 1264
'먹고식당'에서 19.13km
바로가기
연지가든
경상남도 김해시 구산동 933
'먹고식당'에서 20.93km
바로가기
충무횟집
경상남도 창원시 진해구 용원동 1133-11
'먹고식당'에서 22.44km
바로가기
오든
경상남도 창원시 진해구 용원동 1353-6
'먹고식당'에서 22.54km
바로가기
보배반점용원점
경상남도 창원시 진해구 용원동 1213-2 101호,104호
'먹고식당'에서 23.04km
바로가기
주변 전통 시장 (12)
골드테마거리
부산광역시 부산진구 범일로 134 중앙빌딩
'먹고식당'에서 0.7km
바로가기
철뚝시장
부산광역시 부산진구 자유평화로3번길 14-15
'먹고식당'에서 0.73km
바로가기
부산평화시장
부산광역시 부산진구 자유평화로 7
'먹고식당'에서 0.75km
바로가기
범일골목시장
부산광역시 동구 범곡북로 11
'먹고식당'에서 0.78km
바로가기
대현프리몰부산점
부산광역시 부산진구 중앙대로 지하 717
'먹고식당'에서 0.81km
바로가기
서면지하상가
부산광역시 부산진구 중앙대로 지하 717
'먹고식당'에서 0.81km
바로가기
부산자유시장
부산광역시 동구 조방로 48
'먹고식당'에서 0.84km
바로가기
부산진시장
부산광역시 동구 진시장로 24
'먹고식당'에서 1.29km
바로가기
성북시장
부산광역시 동구 성북로 56
'먹고식당'에서 1.32km
바로가기
부산남문시장
부산광역시 동구 범일로65번길 8
'먹고식당'에서 1.35km
바로가기
부전상가
부산광역시 부산진구 중앙대로 755번길 21
'먹고식당'에서 1.38km
바로가기
전포놀이터시장
부산광역시 부산진구 전포대로 256번길 109
'먹고식당'에서 1.48km
바로가기
주변 무료 급식소 (12)
범천2동 무료급식소
부산광역시 부산진구 엄광로 477-1
'먹고식당'에서 0.65km
바로가기
전포종합사회복지관
부산광역시 부산진구 전포대로190번길 35
'먹고식당'에서 1.08km
바로가기
신빈회 요셉의집
부산광역시 부산진구 가야대로703번나길 28
'먹고식당'에서 1.48km
바로가기
자성대노인복지관
부산광역시 동구 자성로140번길 32
'먹고식당'에서 1.52km
바로가기
문현노인복지관
부산광역시 남구 고동골로 11(문현동)
'먹고식당'에서 1.63km
바로가기
부산진구종합재가노인복지관
부산광역시 부산진구 엄광로292
'먹고식당'에서 1.66km
바로가기
부산진구종합재가노인복지센터
부산광역시 부산진구 엄광로292
'먹고식당'에서 1.66km
바로가기
동구무료급식소
부산광역시 동구 증산로 51
'먹고식당'에서 1.82km
바로가기
부산진구노인복지관
부산광역시 부산진구 전포대로300번길 6
'먹고식당'에서 1.93km
바로가기
지게골복지관
부산광역시 남구 지게골로 139-33(문현동)
'먹고식당'에서 2.25km
바로가기
당감종합사회복지관
부산광역시 부산진구 당감서로 16
'먹고식당'에서 2.5km
바로가기
사랑나라
부산광역시 연제구 황령산로 503번길 27-1
'먹고식당'에서 2.91km
바로가기
블로그 리뷰
-
수림식당 방문 후기, 부산탄탄면 먹고 가지만두에 반한 곳 식당의 화려한 입구를 건너면 깔끔한 주택 개조 건물이 보이는데요. 외관부터 기분 좋은 수영맛집 수림식당입니다. 수림식당은 전체적으로 깔끔한...
부산소식커플(20260420)

-
얼마전 의왕 오전동에 위치한 화진식당에서 정말 간만에 찐으로 맛나는 돼지갈비를 먹고 온 후기 올려봐요~ 칼집이 킥이었던 화진식당 프리미엄 특선 돼지갈비 하루에 100인분 한정으로 판매하는 프리미엄...
판다곰과 조련사의 소소한일상(20260501)

-
청송여행 블루리본 잔뜩 닭불고기 맛집 추천 원조신촌식당 닭불백숙 솔직 후기 뽀글뽀글 약수물도 마시고 닭불고기도 먹고! 내돈내산 영업시간 10:00 - 20:30 ( 라스트오더 19:30 ) 오빠가 어릴 적 청송에서 먹었던...
상큼하다라다라(20260511)

-
미강식당 주차도 가능하고 고기도 구워주는 곳이라 편하게 먹고 왔습니다 솔직한 후기 상세하게 작성해 볼게요 영업시간 : 11시 30분~23시 (15시~16시 30분 브레이크 타임) 주말 및 공휴일에는 브레이크 타임 없음...
일리빈 블로그(20260513)

-
"라는 말이 절로 나오는 곳 칼칼한 김치찌개가 먹고 싶다면 로마 한식당 맛집 미담을 기억하세요. 목차 로마 한식당 '미담' 기본 정보 웨이팅, 예약 방법 미담 메뉴판 직접 먹어본 3가지 메뉴 후기 1. 로마...
이대로 따라해보자야(20260608)

-
고반식당 호매실능실점 숙성삼겹살이 유명한 곳이라 기대하고 방문했는데, 직접 먹어보니 왜... 3️⃣ 숙성생삼겹살 & 돈치맛살(항정살) 후기 숙성생삼겹살은 고기가 두툼하게 나와서 처음부터 기대가...
나에게 하는 나의 이야기(20260321)

-
#미야코지마 #미야코지마여행 #미야코지마맛집 #미야코지마식당 #미야코지마저녁 #미야코지마고야식당 #오키나와음식 #오키나와향토요리 #고야참프루 #라후테 #바다포도 #우미부도 #미야코지마맛집추천...
여행 고인물(20260309)

-
지난 2월말에 제주표선 여행을 다녀왔는데요 - 9월에도 맛있게 먹고 또 생각나서 2월에도 간 표선어촌식당 후기 들려드릴게요. 일단은 해비치리조트와 매우 근접해서 도보로 이용해서 편하고요. 운전부담없이...
흥 많은 애미의 인생풀이(20260307)

-
마무리 후기 저는 이번에 청년식당에서 고기국수와 수육정식을 먹었는데요. 국물 맛이 깊고 따뜻해서 만족스럽게 먹었고, 수육정식은 구성 자체가 든든해서 한 끼 식사로 좋았어요. 특히 “오늘은 면이 먹고...
by따뜻한봄날블로그(20260119)

-
밥 먹고 나서 우리 수강생분께서 주신 귀한 아이스크림을 먹었더니 딱- 좋더라구요! 한정식 후 소프트콘 추천드리고 싶어요 입안에 깔끔해지면서 최고의 조합입니당 4 윤식당 방문후기 총정리 한 상이...
울라양의코디하자(20251118)

일별 방문 통계
월별 방문 통계
카카오맵 바로가기
카카오맵 위치 기준 길안내
리뷰 (0)
등록된 리뷰가 없습니다.
관련 지도 선택 및 번역
첨부파일


![[먹고식당] 보통이님의 리뷰 2025/2/24](https://search.pstatic.net/sunny/?type=b150&src=https%3A%2F%2Fd2uja84sd90jmv.cloudfront.net%2Fposts%2F003keJxDbJIEp9soxe4wKw%2Fms.jpg%3Fupdated%3D-62167392000)

![[김보민 칼럼] 밥먹고놀자 식당을 시작하며](https://search.pstatic.net/common/?type=b150&src=http%3A%2F%2Fimgnews.naver.net%2Fimage%2F5513%2F2022%2F01%2F20%2F2022011808381469_20220120213410443.jpg)

![성훈, 식당 비매너 논란…집게로 고기 먹고·땀 털고 [엑s 이슈]](https://search.pstatic.net/common/?type=b150&src=http%3A%2F%2Fimgnews.naver.net%2Fimage%2F311%2F2022%2F08%2F10%2F0001486998_001_20220810082701564.jpg)


![[감나무집 기사식당] 먹고 마시는 김씨님의 별로 포스트 2020/7/27](https://search.pstatic.net/sunny/?type=b150&src=https%3A%2F%2Fd2uja84sd90jmv.cloudfront.net%2Fposts%2FEztv8KOZ7k_SextT58aarw%2Fm.jpg)
![[New] The 10 All-Time Best Home Decor (in the World) - 190316 #홍대 #바류식당 삼겹살이 너무 먹고 싶었다. _ | Food, Pretzel...](https://search.pstatic.net/sunny/?type=b150&src=https%3A%2F%2Fi.pinimg.com%2Foriginals%2F59%2Fb5%2F54%2F59b5547cb7d01aaf705a023c91ec6ea8.jpg)